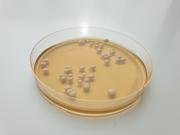

Mitsubishi Tanabe Pharma America Presents New Results of RADICAVA ORS® (edaravone)
Mitsubishi Tanabe Pharma America, Inc. (MTPA) today announced new findings from two studies of RADICAVA ORS® (edaravone) presented at the Northeast Amyotrophic Lateral Sclerosis Consortium (NEALS) 2024 Annual Meeting. The company presented results from the MT-1186-A04 Study, a Phase 3b extension of the previously reported MT-1186-A02 study which explored the superiority of investigational once daily dosing versus the FDA-approved on/off regimen of RADICAVA ORS in people living with ALS. MTPA also shared results from primary and post-hoc analyses of RADICAVA ORS compared with Pooled Resource Open-Access ALS Clinical Trials (PRO-ACT) historical placebo controls, with evidence suggesting treatment with RADICAVA ORS increased survival outcomes and decreased physical function decline versus controls. Poster Presentation: Phase 3b Extension Study MT-1186-A04 to Evaluate the Continued Efficacy and Safety of Radicava ORS® (Oral Edaravone) for up to an Additional 48 Weeks in Patients with Amyotrophic…